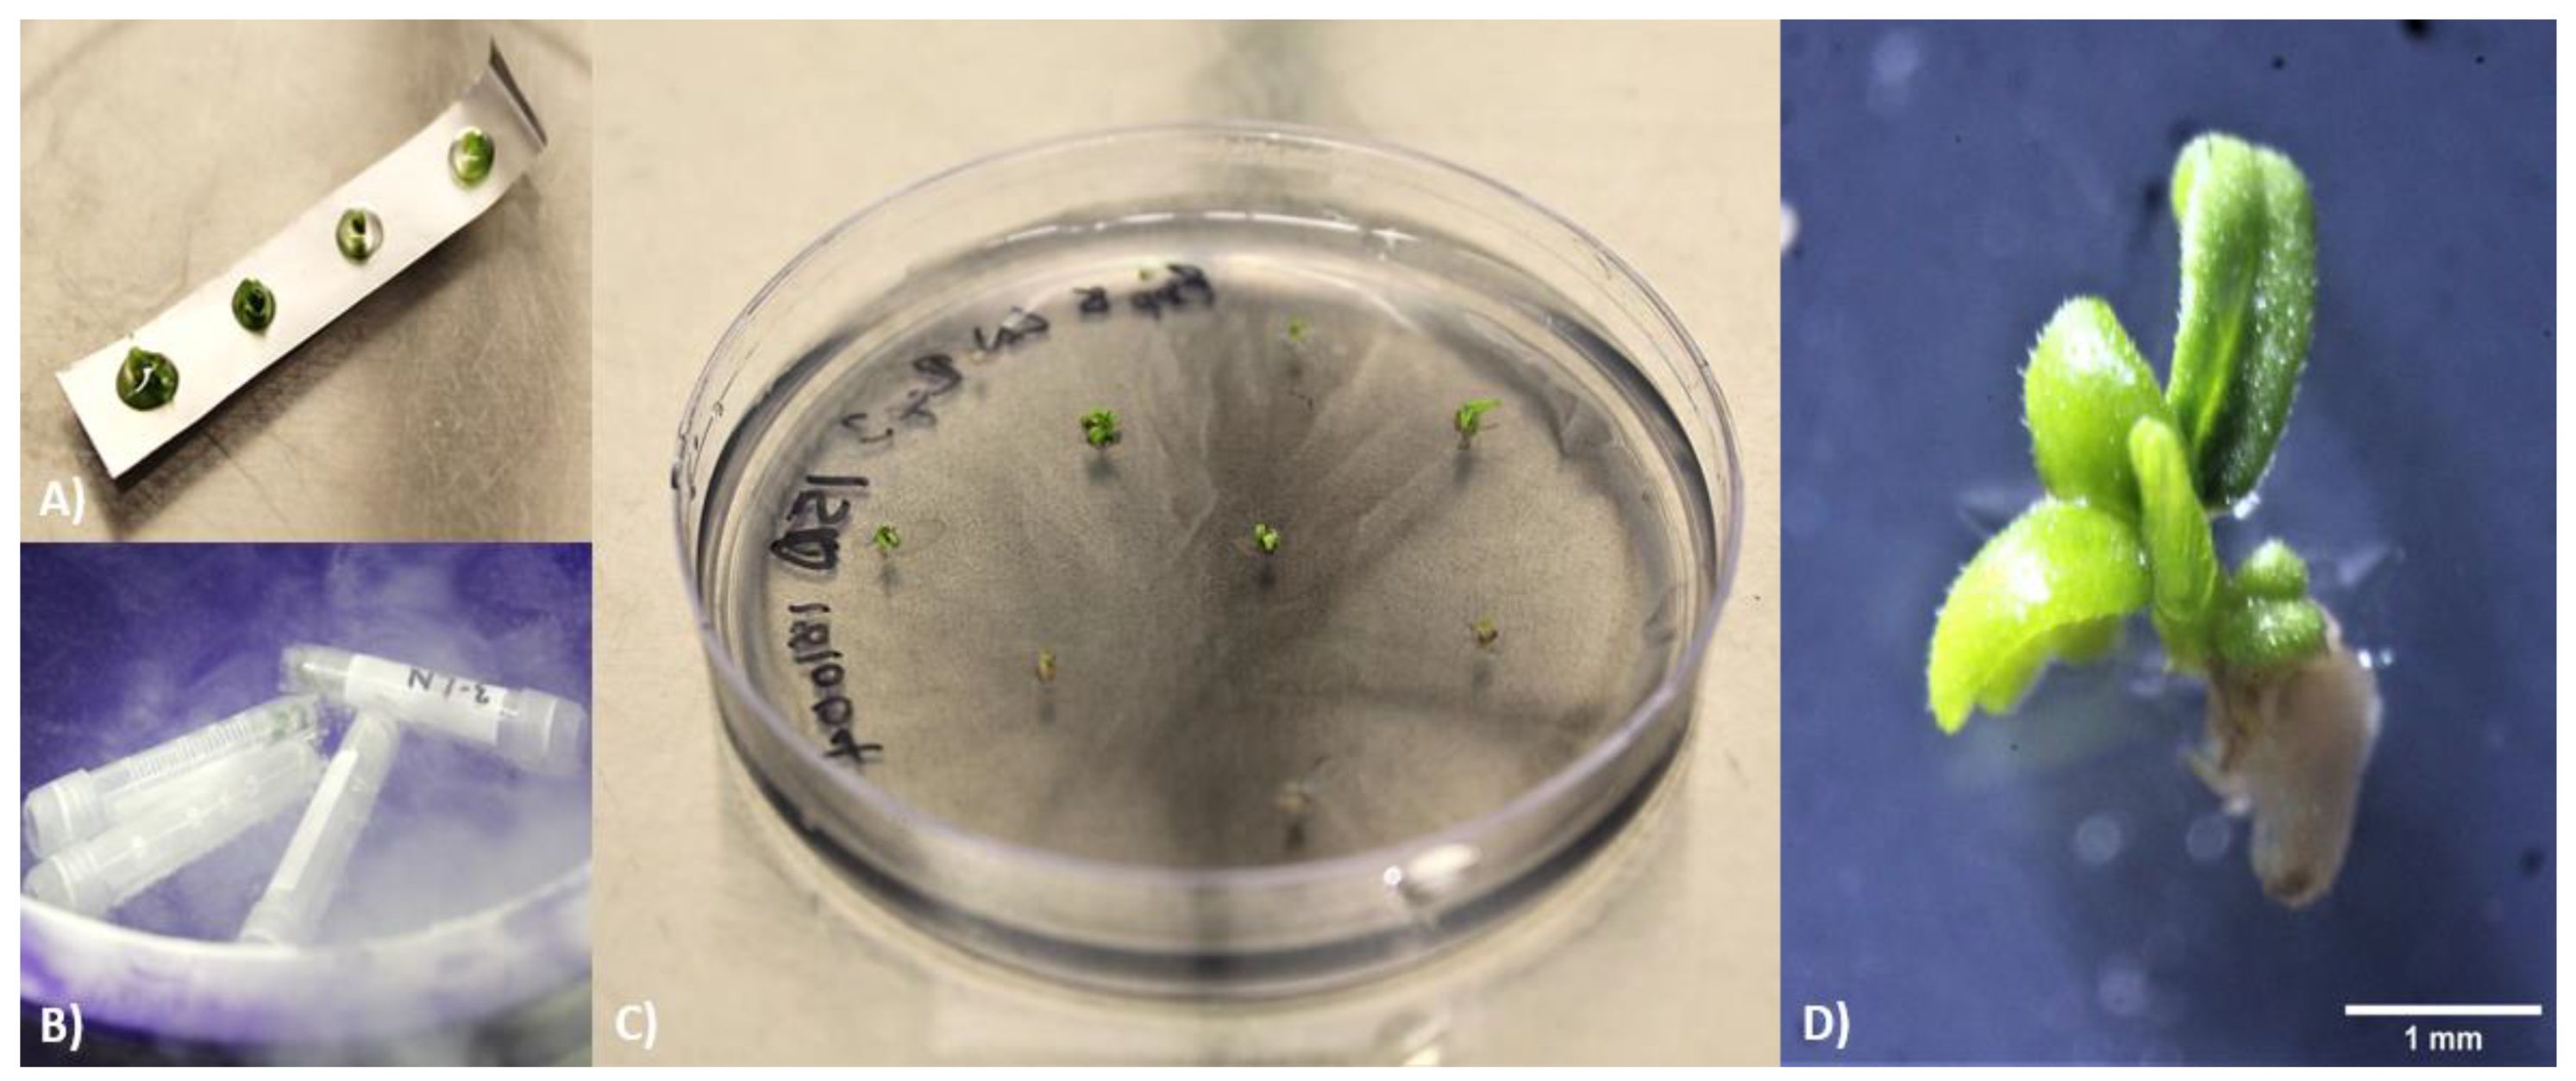

Cryopreservation of 13 Commercial Cannabis sativa Genotypes Using In Vitro Nodal Explants
Abstract
1. Introduction
2. Materials and Methods
2.1. Plant Material
2.1.1. Explant Preparation and Surface Sterilization
2.1.2. Donor Plant Initiation
2.1.3. Donor Plant Maintenance
2.2. Cryopreservation Protocol
2.2.1. Conditioning
2.2.2. Vitrification
2.2.3. Vitrification—Droplet
2.2.4. Vitrification—Conventional
2.2.5. Recovery Preparation
2.2.6. Recovery and Data Assessment
2.2.7. Growth Conditions for Recovering Samples
2.2.8. Experiment—Recovery Media
2.2.9. Experiment—Cold Incubation of Donor Plants
2.2.10. Experiment—Extension of Incubation in Darkness
- (1)
- Darkness: 5 days, gradual light: 5 days, ambient light: 20 days
- (2)
- Darkness: 10 days, gradual light: 5 days, ambient light: 15 days
- (3)
- Darkness: 15 days, gradual light: 5 days, ambient light: 10 days
- (4)
- Darkness: 20 days, gradual light: 5 days, ambient light: 5 days
- (5)
- Darkness: 7 days, gradual light: 7 days, ambient light: 16 days
- (6)
- Darkness: 14 days, gradual light: 7 days, ambient light: 9 days
- (7)
- Darkness: 14 days, gradual light: 0 days, ambient light: 16 days
- (8)
- Darkness: 21 days, gradual light: 7 days, ambient light: 2 days
2.2.11. Experiment—Comparison of PVS3 and PVS2
2.2.12. Growth Conditions for Donor Plants and Recovered Cultures
2.2.13. Experiment—Cultivar Response to Cryopreservation Protocol
2.2.14. Evaluation of Cryopreserved Plants
2.2.15. Vegetative Growth
2.2.16. Flower Induction
2.2.17. Bud and Trim Harvest
2.2.18. Moisture Analysis
2.2.19. Cannabinoid and Terpene Detection and Quantification
2.3. Statistical Analysis
3. Results and Discussion
3.1. Pre- and Post-Cryopreservation Conditions
3.1.1. Recovery Media
3.1.2. Cold Incubation of Donor Plants
3.1.3. Extension of Incubation in Darkness
3.2. Duration of Vitrification Treatment
3.3. Droplet Vitrification vs. Cryo Vial Vitrification
3.4. Genotypic Variation
3.5. Evaluation of Ex Vitro Cultivated Cryopreserved Plants
4. Conclusions
Supplementary Materials
Author Contributions
Funding
Institutional Review Board Statement
Informed Consent Statement
Data Availability Statement
Acknowledgments
Conflicts of Interest
References
- Bansal, A.; Chhabra, V.; Rawal, R.; Sharma, S. Chemometrics: A new scenario in herbal drug standardization. J. Pharm. Anal. 2014, 4, 223–233. [Google Scholar] [CrossRef]
- Radwan, M.M.; Chandra, S.; Gul, S.; ElSohly, M.A. Cannabinoids, Phenolics, Terpenes and Alkaloids of Cannabis. Molecules 2021, 26, 2774. [Google Scholar] [CrossRef]
- Russo, E.B. The Case for the Entourage Effect and Conventional Breeding of Clinical Cannabis: No “Strain,” No Gain. Front. Plant Sci. 2019, 9, 1969. [Google Scholar] [CrossRef] [PubMed]
- LaVigne, J.E.; Hecksel, R.; Keresztes, A.; Streicher, J.M. Cannabis sativa terpenes are cannabimimetic and selectively enhance cannabinoid activity. Sci. Rep. 2021, 11, 1–15. [Google Scholar] [CrossRef] [PubMed]
- Hesami, M.; Pepe, M.; Alizadeh, M.; Rakei, A.; Baiton, A.; Jones, A.M.P. Recent advances in cannabis biotechnology. Ind. Crop. Prod. 2020, 158, 113026. [Google Scholar] [CrossRef]
- Caplan, D.; Stemeroff, J.; Dixon, M.; Zheng, Y. Vegetative propagation of cannabis by stem cuttings: Effects of leaf number, cutting position, rooting hormone, and leaf tip removal. Can. J. Plant Sci. 2018, 98, 1126–1132. [Google Scholar] [CrossRef]
- Campbell, L.G.; Naraine, S.G.U.; Dusfresne, J. Phenotypic plasticity influences the success of clonal propagation in industrial pharmaceutical Cannabis sativa. PLoS ONE 2019, 14, e0213434. [Google Scholar] [CrossRef] [PubMed]
- Monthony, A.; Page, S.; Hesami, M.; Jones, A. The Past, Present and Future of Cannabis sativa Tissue Culture. Plants 2021, 10, 185. [Google Scholar] [CrossRef]
- Muller, H.J. Some Genetic Aspects of Sex. Am. Nat. 1932, 66, 118–138. [Google Scholar] [CrossRef]
- Felsenstein, J. The evolutionary advantage of recombination. Genetics 1974, 78, 737–756. [Google Scholar] [CrossRef]
- Adamek, K.; Torkamaneh, D.; Jones, A.M.P. Accumulation of somatic mutations leads to genetic mosaicism in Cannabis. bioRxiv 2021. [Google Scholar] [CrossRef]
- Diwan, D.; Komazaki, S.; Suzuki, M.; Nemoto, N.; Aita, T.; Satake, A.; Nishigaki, K. Systematic genome sequence differences among leaf cells within individual trees. BMC Genom. 2014, 15, 142. [Google Scholar] [CrossRef] [PubMed][Green Version]
- Lata, H.; Chandra, S.; Khan, I.A.; ElSohly, M.A. In vitro propagation of Cannabis sativa L. and evaluation of regenerated plants for genetic fidelity and cannabinoids content for quality assurance. In Protocols for In Vitro Cultures and Secondary Metabolite Analysis of Aromatic and Medicinal Plants, 2nd ed.; Springer: Berlin/Heidelberg, Germany, 2016; pp. 275–288. [Google Scholar]
- Bairu, M.W.; Aremu, A.O.; Van Staden, J. Somaclonal variation in plants: Causes and detection methods. Plant Growth Regul. 2011, 63, 147–173. [Google Scholar] [CrossRef]
- Schoen, D.J.; Schultz, S.T. Somatic mutation and evolution in plants. Annu. Rev. Ecol. Evol. Syst. 2019, 50, 49–73. [Google Scholar] [CrossRef]
- Popova, E.; Shukla, M.; Kim, H.H.; Saxena, P.K. Plant Cryopreservation for Biotechnology and Breeding. Advances in Plant Breeding Strategies: Breeding, Biotechnology and Molecular Tools; Springer: Berlin/Heidelberg, Germany, 2015; pp. 63–93. [Google Scholar]
- Li, D.-Z.; Pritchard, H.W. The science and economics of ex situ plant conservation. Trends Plant Sci. 2009, 14, 614–621. [Google Scholar] [CrossRef]
- Jekkel, Z.; Heszky, L.E.; Ali, A.H. Effect of different cryoprotectants and transfer temperatures on the survival rate of hemp (Cannabis sativa L.) cell suspension in deep freezing. Acta Biol. Hung. 1989, 40, 127–136. [Google Scholar]
- Lata, H.; Uchendu, E.; Chandra, S.; Majumdar, C.G.; Khan, I.A.; ElSohly, M.A. Cryopreservation of axillary buds of Cannabis sativa L. by V-cryoplate droplet-vitrification: The critical role of sucrose preculture. Cryoletters 2019, 40, 291–298. [Google Scholar] [PubMed]
- Uchendu, E.; Lata, H.; Chandra, S.; Khan, I.A.; ElSohly, M.A. Cryopreservation of shoot tips of elite cultivars of Cannabis sativa L. by droplet vitrification. Med. Cannabis Cannabinoids 2019, 2, 29–34. [Google Scholar] [CrossRef]
- Page, S.R.G.; Monthony, A.S.; Jones, A.M.P. DKW basal salts improve micropropagation and callogenesis compared with MS basal salts in multiple commercial cultivars of Cannabis sativa. Botany 2021, 99, 269–279. [Google Scholar] [CrossRef]
- Monthony, A.S.; Kyne, S.T.; Grainger, C.M.; Jones, A.M.P. Recalcitrance of Cannabis sativa to de novo regeneration; a multi-genotype replication study. PLoS ONE 2021, 16, e0235525. [Google Scholar] [CrossRef]
- Murashige, T.; Skoog, F. A Revised Medium for Rapid Growth and Bio Assays with Tobacco Tissue Cultures. Physiol. Plant. 1962, 15, 473–497. [Google Scholar] [CrossRef]
- R Core Team. R: A Language and Environment for Statistical Computing; R Foundation for Statistical Computing: Vienna, Austria, 2013; Available online: https://www.R-project.org/ (accessed on 28 June 2021).
- Ozudogru, E.A.; Kirdok, E.; Kaya, E.; Capuana, M.; Benelli, C.; Engelmann, F. Cryopreservation of redwood (Sequoia sempervirens (D. Don.) Endl.) in vitro buds using vitrification-based techniques. Cryo Lett. 2011, 32, 99–110. [Google Scholar]
- Gaspar, T.; Kevers, C.; Penel, C.; Greppin, H.; Reid, D.M.; Thorpe, T.A. Plant hormones and plant growth regulators in plant tissue culture. Vitr. Cell. Dev. Biol. Plant 1996, 32, 272–289. [Google Scholar] [CrossRef]
- Popova, E.; Bukhov, N.; Popov, A.; Kim, H.-H. Cryopreservation of protocorm-like bodies of the hybrid orchid Bratonia (Miltonia flavescens × Brassia longissimi). Cryo Lett. 2010, 31, 426–437. [Google Scholar]
- Lorenzo, J.C.; González, B.L.; Escalona, M.; Teisson, C.; Espinosa, P.; Borroto, C. Sugarcane shoot formation in an improved temporary immersion system. Plant Cell Tissue Organ Cult. (PCTOC) 1998, 54, 197–200. [Google Scholar] [CrossRef]
- Chang, Y.; Reed, B. Extended alternating-temperature cold acclimation and culture duration improve pear shoot cryopreservation. Cryobiology 2000, 40, 311–322. [Google Scholar] [CrossRef] [PubMed]
- Reed, B. Pre-treatment strategies for cryopreservation of plant tissues. In In Vitro Conservation of Plant Genetic Resources; Normah, M.N., Narimah, M.K., Clyde, M.M., Eds.; Universiti Kebangsaan: Bangi Selangor, Malaysia, 1996; pp. 73–87. [Google Scholar]
- Edesi, J.; Kotkas, K.; Pirttilä, A.M.; Häggman, H. Does light spectral quality affect survival and regeneration of potato (Solanum tuberosum L.) shoot tips after cryopreservation? Plant Cell Tissue Organ Cult PCTOC 2014, 119, 599–607. [Google Scholar] [CrossRef]
- Jones, A.M.P.; Saxena, P.K. Inhibition of phenylpropanoid biosynthesis in Artemisia annua L.: A novel approach to reduce oxidative browning in plant tissue culture. PLoS ONE 2013, 8, e76802. [Google Scholar] [CrossRef]
- Preece, J.E.; Compton, M.E. Problems with explant exudation in micropropagation. In High-Tech and Micropropagation I; Springer: Berlin/Heidelberg, Germany, 1991; pp. 168–189. [Google Scholar]
- Uchendu, E.E.; Shukla, M.R.; Reed, B.M.; Saxena, P.K. Melatonin enhances the recovery of cryopreserved shoot tips of A merican elm (U lmus americana L.). J. Pineal Res. 2013, 55, 435–442. [Google Scholar] [CrossRef]
- Rathwell, R.; Shukla, M.R.; Jones, A.M.P.; Saxena, P.K.; Jones, M. In vitro propagation of cherry birch (Betula lenta L.). Can. J. Plant Sci. 2016, 96, 571–578. [Google Scholar] [CrossRef]
- Salama, A.; Popova, E.; Jones, M.P.; Shukla, M.R.; Fisk, N.S.; Saxena, P.K. Cryopreservation of the critically endangered golden paintbrush (Castilleja levisecta Greenm.): From nature to cryobank to nature. Vitr. Cell. Dev. Biol.-Anim. 2018, 54, 69–78. [Google Scholar] [CrossRef]
- Engelmann, F. Plant cryopreservation: Progress and prospects. Vitr. Cell. Dev. Biol.-Anim. 2004, 40, 427–433. [Google Scholar] [CrossRef]
- Lee, Y.-G.; Popova, E.; Cui, H.-Y.; Kim, H.-H.; Park, S.-U.; Bae, C.-H.; Lee, S.-C.; Engelmann, F. Improved cryopreservation of chrysanthemum (Chrysanthemum morifolium) using droplet-vitrification. Cryo Lett. 2012, 32, 487–497. [Google Scholar]
- Samuels, F.; Stich, D.; Bonnart, R.; Volk, G.; Levinger, N. Non-Uniform Distribution of Cryoprotecting Agents in Rice Culture Cells Measured by CARS Microscopy. Plants 2021, 10, 589. [Google Scholar] [CrossRef]
- Volk, G.M.; Caspersen, A.M. Cryoprotectants and components induce plasmolytic responses in sweet potato (Ipomoea batatas (L.) Lam.) suspension cells. Vitr. Cell. Dev. Biol.-Anim. 2017, 53, 363–371. [Google Scholar] [CrossRef]

| Cryopreservation Treatment | Freezing Method | Recovery Media | Survival (%) | Regrowth (%) |
|---|---|---|---|---|
| Control | N/A | HalfSMM | 100 ± 0 | 90 ± 10 abc |
| N/A | HalfSMM + GA3 | 100 ± 0 | 96.7 ± 3.3 a | |
| N/A | MSbasal | 100 ± 0 | 95 ± 2.9 ab | |
| N/A | MSbasal + GA3 | 100 ± 0 | 100 ± 0 a | |
| N/A | SMM | 100 ± 0 | 93.3 ± 3.3 ab | |
| no LN2 | Droplet Vitrification | HalfSMM | 76.7 ± 10.9 | 60 ± 12.6 cdef |
| Droplet Vitrification | HalfSMM + GA3 | 66.7 ± 9.9 | 50 ± 13.4 def | |
| Droplet Vitrification | MSbasal | 75 ± 5 | 35 ± 9.6 defg | |
| Cryogenic vial | MSbasal | 80 ± 11.5 | 50 ± 17.3 | |
| Droplet Vitrification | MSbasal + GA3 | 85 ± 9.6 | 75 ± 5 cdef | |
| Cryogenic vial | MSbasal + GA3 | 55 ± 9.6 | 55 ± 9.6 | |
| Droplet Vitrification | SMM | 85 ± 9.6 | 69.2 ± 15 abcd | |
| Cryogenic vial | SMM | 80 ± 8.2 | 55 ± 12.6 | |
| LN2 | Droplet Vitrification | HalfSMM | 33.3 ± 6.7 | 20 ± 0 fg |
| Droplet Vitrification | HalfSMM + GA3 | 43.3 ± 6.1 | 23.3 ± 3.3 fg | |
| Droplet Vitrification | MSbasal | 50 ± 5.8 | 30 ± 12.9 efg | |
| Cryogenic vial | MSbasal | 55 ± 20.6 | 10 ± 10 | |
| Droplet Vitrification | MSbasal + GA3 | 30 ± 5.8 | 15 ± 15 fg | |
| Cryogenic vial | MSbasal + GA3 | 30 ± 5.8 | 20 ± 8.2 | |
| Droplet Vitrification | SMM | 30 ± 11.3 | 3.3 ± 3.3 g | |
| Cryogenic vial | SMM | 65 ± 5 | 15 ± 5 |
| Genotype | Treatment | |||||
|---|---|---|---|---|---|---|
| Control | No LN | LN | ||||
| Survival (%) | Regrowth (%) | Survival (%) | Regrowth (%) | Survival (%) | Regrowth (%) | |
| Cultivar 1 | 100 ± 0 | 100 ± 0 a | 95 ± 5 | 85 ± 5 abcde | 80 ± 10 | 60 ± 10 bcdefg |
| Cultivar 2 | 100 ± 0 | 93.3 ± 3.3 ab | 100 ± 0 | 90 ± 10 abc | 80 ± 5.8 | 66.7 ± 3.3 abcdefg |
| Cultivar 3 | 100 ± 0 | 95 ± 5 a | 95 ± 5 | 85 ± 5 abcde | 70 ± 0 | 35 ± 15 efg |
| Cultivar 4 | 100 ± 0 | 100 ± 0 a | 90 ± 0 | 90 ± 0 abcde | 60 ± 0 | 45 ± 5 defg |
| Cultivar 5 | 86.7 ± 11.6 | 37.4 ± 14.1 efg | 83.3 ± 5.8 | 66.7 ± 5.8 abcdefg | 60 ± 26.5 | 43.3 ± 25.2 cdefg |
| Cultivar 6 | 76.7 ± 15.3 | 30 ± 25.2 fg | 80 ± 5.8 | 70 ± 5.8 abcdefg | 63.3 ± 15.3 | 50 ± 10 bcdefg |
| Cultivar 7 | 93.3 ± 5.8 | 83.3 ± 5.8 abcd | 83.3 ± 11.6 | 70 ± 10 abcdefg | 43.3 ± 15.3 | 30 ± 10 fg |
| Cultivar 8 | 100 ± 0 | 96.7 ± 3.3 a | 80 ± 11.6 | 70 ± 5.8 abcdefg | 60 ± 10 | 43.3 ± 8.8 cdefg |
| Cultivar 9 | 93.3 ± 6.7 | 76.7 ± 6.7 bcde | 86.7 ± 6.7 | 66.7 ± 8.8 abcdefg | 50 ± 15.3 | 26.7 ± 12 g |
| Cultivar 10 | 93.3 ± 3.3 | 76.7 ± 8.8 bcde | 86.7 ± 8.8 | 60 ± 5.8 abcdefg | 73.3 ± 8.8 | 26.7 ± 8.8 g |
| Cultivar 11 | 86.7 ± 13.3 | 73.3 ± 17.6 abcdef | 80 ± 5.8 | 70 ± 10 abcdefg | 80 ± 10 | 50 ± 5.8 bcdefg |
| Cultivar 12 | 99.3 ± 3.3 | 70 ± 5.8 abcdefg | 70 ± 0 | 66.6 ± 3.3 abcdefg | 66.7 ± 8.8 | 43.3 ± 8.8 cdefg |
| Cultivar 13 | 100 ± 0 | 93.3 ± 6.7 ab | 90 ± 5.8 | 43.3 ± 8.8 cdefg | 66.7 ± 8.8 | 46.7 ± 6.7 cdefg |
| Cryopreservation Treatment | Whole Plant Fresh Weight (g) | Stem Fresh Weight (g) | Trim Fresh Weight (g) | Bud Fresh Weight (g) |
|---|---|---|---|---|
| Control | 3007.7 ± 101.7 | 196.5 ± 20 | 272 ± 45.6 | 258 ± 39.9 |
| no LN2 | 3033.5 ± 216.5 | 173 ± 31 | 306 ± 96 | 273.5 ± 89.5 |
| LN2 | 3108 ± 296 | 186.5 ± 50.5 | 332.5 ± 163.5 | 308 ± 82 |
| Cryopreservation Treatment | Trim Dry Weight (g) | Trim Moisture Content (g) | Bud Dry Weight (g) | Bud Moisture Content (%) | Dry Bud Yield per Plant (g/g) |
|---|---|---|---|---|---|
| Control | 46.1 ± 3.8 | 81.9 ± 3.6 | 54 ± 8.9 | 79.1 ± 0.3 | 0.018 ± 0.002 |
| no LN2 | 45.3 ± 12.5 | 82.2 ± 9.7 | 51 ± 13 | 80.9 ± 1.2 | 0.017 ± 0.003 |
| LN2 | 34.6 ± 1.3 | 86.1 ± 7.2 | 63.3 ± 16.3 | 79.4 ± 0.2 | 0.02 ± 0.003 |
| Bud | Trim | |||||
|---|---|---|---|---|---|---|
| Control | no LN2 | LN2 | Control | no LN2 | LN2 | |
| CBDV | 0.13 ± 0.02 a | 0.045 ± 0.05 b | 0 b | 0.01 ± 0.006 a | 0.01 ± 0.01 a | 0 a |
| CBC | 0.025 ± 0.02 a | 0 a | 0 a | 0 a | 0 a | 0 a |
| d8THC | 0.025 ± 0.003 a | 0.01 ± 0 b | 0.01 ± 0 ab | 0 a | 0 a | 0 a |
| CBG | 0.14 ± 0.01 a | 0.06 ± 0.06 b | 0 b | 0.0032 ± 0.003 a | 0.015 ± 0.02 b | 0 b |
| CBGA | 0.33 ± 0.03 a | 0.2 ± 0.1 b | 0.065 ± 0.005 b | 0.095 ± 0.01 a | 0.04 ± 0.04 b | 0.005 ± 0.005 b |
| CBD | 0 b | 0.065 ± 0.07 a | 0.14 ± 0.02 a | 0 a | 0 a | 0 a |
| CBDA | 0.07 ± 0.004 a | 0.03 ± 0.03 b | 0.01 ± 0.01 b | 0.018 ± 0.003 a | 0.01 ± 0.01 ab | 0 b |
| d9THC | 0.73 ± 0.09 a | 0.68 ± 0.1 a | 0.55 ± 0.005 a | 0.29 ± 0.01 a | 0.22 ± 0.04 b | 0.15 ± 0.01 b |
| d9THCA | 11.18 ± 0.9 a | 11.1 ± 1.2 a | 12.7 ± 0.9 a | 3.67 ± 0.3 a | 2.83 ± 0.5 b | 2.97 ± 0.4 ab |
| Total | 12.54 ± 1 a | 12.14 ± 0.9 a | 13.49 ± 1 a | 4.27 ± 0.4 a | 3.11 ± 0.6 b | 3.13 ± 0.4 ab |
| Bud | Trim | |||||
|---|---|---|---|---|---|---|
| Control | no LN2 | LN2 | Control | no LN2 | LN2 | |
| α-pinene | 0.073 ± 0.005 | 0.048 ± 0.01 | 0 | 0.025 ± 0.001 | 0.027 ± 0.004 | 0 |
| β-pinene | 0.083 ± 0.006 | 0.056 ± 0 | 0.076 ± 0 | 0.029 ± 0 | 0.03 ± 0 | 0.033 ± 0 |
| Myrcene | 0.34 ± 0.04 | 0.25 ± 0.08 | 0.41 ± 0.2 | 0 | 0 | 0 |
| Carene | 0.019 ± 0.002 | 0.013 ± 0.004 | 0 | 0.006 ± 0.0003 | 0.0067 ± 0.002 | 0 |
| α-terpinene | 0.026 ± 0.002 | 0.014 ± 0.005 | 0.021 ± 0.01 | 0.0063 ± 0.0004 | 0.0066 ± 0.002 | 0.0065 ± 0.003 |
| ρ-cymene | 0.011 ± 0 | 0.016 ± 0.004 | 0.023 ± 0.01 | 0 | 0 | 0 |
| Limonene | 0.013 ± 0.001 | 0.011 ± 0.0004 | 0.016 ± 0.007 | 0.0051 ± 0.0004 | 0.0071 ± 0.001 | 0 |
| Ocimene | 0.038 ± 0.004 | 0.033 ± 0.008 | 0.051 ± 0.02 | 0.017 ± 0.001 | 0.022 ± 0.004 | 0.02 ± 0.002 |
| δ-terpinene | 0.018 ± 0.001 | 0.01 ± 0.003 | 0.014 ± 0.006 | 0.0087 ± 0.0003 | 0.0048 ± 0.001 | 0.0045 ± 0.002 |
| Terpinolene | 0.25 ± 0.03 | 0.16 ± 0.05 | 0.25 ± 0.1 | 0.06 ± 0.005 | 0.065 ± 0.02 | 0.065 ± 0.02 |
| Linalool | 0.02 ± 0.002 | 0.013 ± 0.004 | 0.018 ± 0.007 | 0.0087 ± 0.0007 | 0.0099 ± 0.0007 | 0.01 ± 0.002 |
| Osipulegol | 0.011 ± 0.001 | 0.0073 ± 0.001 | 0.012 ± 0.005 | 0.0041 ± 0.0004 | 0.0047 ± 0.001 | 0.0033 ± 0.003 |
| β-caryophyllene | 0.07 ± 0.003 | 0.063 ± 0.01 | 0.071 ± 0.03 | 0.076 ± 0.004 | 0.097 ± 0.01 | 0.09 ± 0.001 |
| α-humulene | 0.014 ± 0.0006 | 0.014 ± 0.003 | 0.016 ± 0.006 | 0.017 ± 0.0009 | 0.022 ± 0.002 | 0.02 ± 0.0006 |
| Nerolidol 2 | 0.6 ± 0.04 | 0.46 ± 0.09 | 0.52 ± 0.2 | 0.47 ± 0.03 | 0.53 ± 0.07 | 0.49 ± 0.2 |
| Guaiol | 0.014 ± 0.01 | 0.025 ± 0.02 | 0.057 ± 0.008 | 0 | 0.025 ± 0.03 | 0.03 ± 0.03 |
| α-terpineol | 0.048 ± 0.004 | 0.037 ± 0.009 | 0.044 ± 001 | 0.021 ± 0.002 | 0.023 ± 0.004 | 0.014 ± 0.01 |
| Total | 1.64 ± 0.1 | 1.23 ± 0.3 | 1.69 ± 0.7 | 0.83 ± 0.05 | 0.933 ± 0.2 | 0.92 ± 0.3 |
Publisher’s Note: MDPI stays neutral with regard to jurisdictional claims in published maps and institutional affiliations. |
© 2021 by the authors. Licensee MDPI, Basel, Switzerland. This article is an open access article distributed under the terms and conditions of the Creative Commons Attribution (CC BY) license (https://creativecommons.org/licenses/by/4.0/).
Share and Cite
Downey, C.D.; Golenia, G.; Boudko, E.A.; Jones, A.M.P. Cryopreservation of 13 Commercial Cannabis sativa Genotypes Using In Vitro Nodal Explants. Plants 2021, 10, 1794. https://doi.org/10.3390/plants10091794
Downey CD, Golenia G, Boudko EA, Jones AMP. Cryopreservation of 13 Commercial Cannabis sativa Genotypes Using In Vitro Nodal Explants. Plants. 2021; 10(9):1794. https://doi.org/10.3390/plants10091794
Chicago/Turabian StyleDowney, Cassandra D., Gregory Golenia, Ekaterina A. Boudko, and Andrew Maxwell P. Jones. 2021. "Cryopreservation of 13 Commercial Cannabis sativa Genotypes Using In Vitro Nodal Explants" Plants 10, no. 9: 1794. https://doi.org/10.3390/plants10091794
APA StyleDowney, C. D., Golenia, G., Boudko, E. A., & Jones, A. M. P. (2021). Cryopreservation of 13 Commercial Cannabis sativa Genotypes Using In Vitro Nodal Explants. Plants, 10(9), 1794. https://doi.org/10.3390/plants10091794
